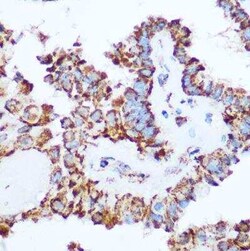
Pyruvate Dehydrogenase E1-alpha subunit Antibody - Azide and BSA Free,

missing translation for 'onlineSavingsMsg'
Learn More
Learn More
Pyruvate Dehydrogenase E1-alpha subunit Antibody - Azide and BSA Free, Novus Biologicals™
Rabbit Polyclonal Antibody
Brand: Novus Biologicals NBP2-95251-0.1ml
This item is not returnable.
View return policy
Description
Pyruvate Dehydrogenase E1-alpha subunit Polyclonal antibody specifically detects Pyruvate Dehydrogenase E1-alpha subunit in Human, Mouse, Rat samples. It is validated for Western Blot, Immunohistochemistry, Immunocytochemistry/ Immunofluorescence, Immunoprecipitation, Immunohistochemistry (Paraffin)
Specifications
| Pyruvate Dehydrogenase E1-alpha subunit | |
| Polyclonal | |
| Western Blot 1:500 - 1:1000, Immunohistochemistry 1:50-1:200, Immunocytochemistry/ Immunofluorescence 1:50-1:200, Immunoprecipitation 1:20-1:50, Immunohistochemistry-Paraffin | |
| EC 1.2.4.1, PDHA, PDHE1-A type I, PHE1APDHCE1A, pyruvate dehydrogenase (lipoamide) alpha 1, pyruvate dehydrogenase complex, E1-alpha polypeptide 1, pyruvate dehydrogenase E1 component subunit alpha, somatic form, mitochondrial | |
| Recombinant fusion protein containing a sequence corresponding to amino acids 30-390 of human Pyruvate Dehydrogenase E1-alpha subunit (NP_000275.1). FANDATFEIKKCDLHRLEEGPPVTTVLTREDGLKYYRMMQTVRRMELKADQLYKQKIIRGFCHLCDGQEACCVGLEAGINPTDHLITAYRAHGFTFTRGLSVREILAELTGRKGGCAKGKGGSMHMYAKNFYGGNGIVGAQVPLGAGIALACKYNGKDEVCLTLYGDGAANQGQIFEAYNMAALWKLPCIFICENNRYGMGTSVERAAASTDYYKRGDFIPGLRVDGMDILCVREATRFAAAYCRSGKGPILMELQTYRYHGHSMSDPGVSYRTREEIQEVRSKSDPIMLLKDRMVNSNLASVEELKEIDVEVRKEIEDAAQFATADPEPPLEELGYHIYSSDPPFEVRGANQWIKFKSVS | |
| 0.1 mL | |
| Cancer, Core ESC Like Genes, Lipid and Metabolism, Signal Transduction, Stem Cell Markers | |
| 5160 | |
| Store at -20°C. Avoid freeze-thaw cycles. | |
| IgG |
| Western Blot, Immunohistochemistry, Immunofluorescence, Immunoprecipitation, Immunohistochemistry (Paraffin) | |
| Unconjugated | |
| PBS (pH 7.3), 50% glycerol | |
| Rabbit | |
| Affinity purified | |
| RUO | |
| Primary | |
| Human, Mouse, Rat | |
| Purified |
Product Content Correction
Your input is important to us. Please complete this form to provide feedback related to the content on this product.
Product Title
Spot an opportunity for improvement?Share a Content Correction